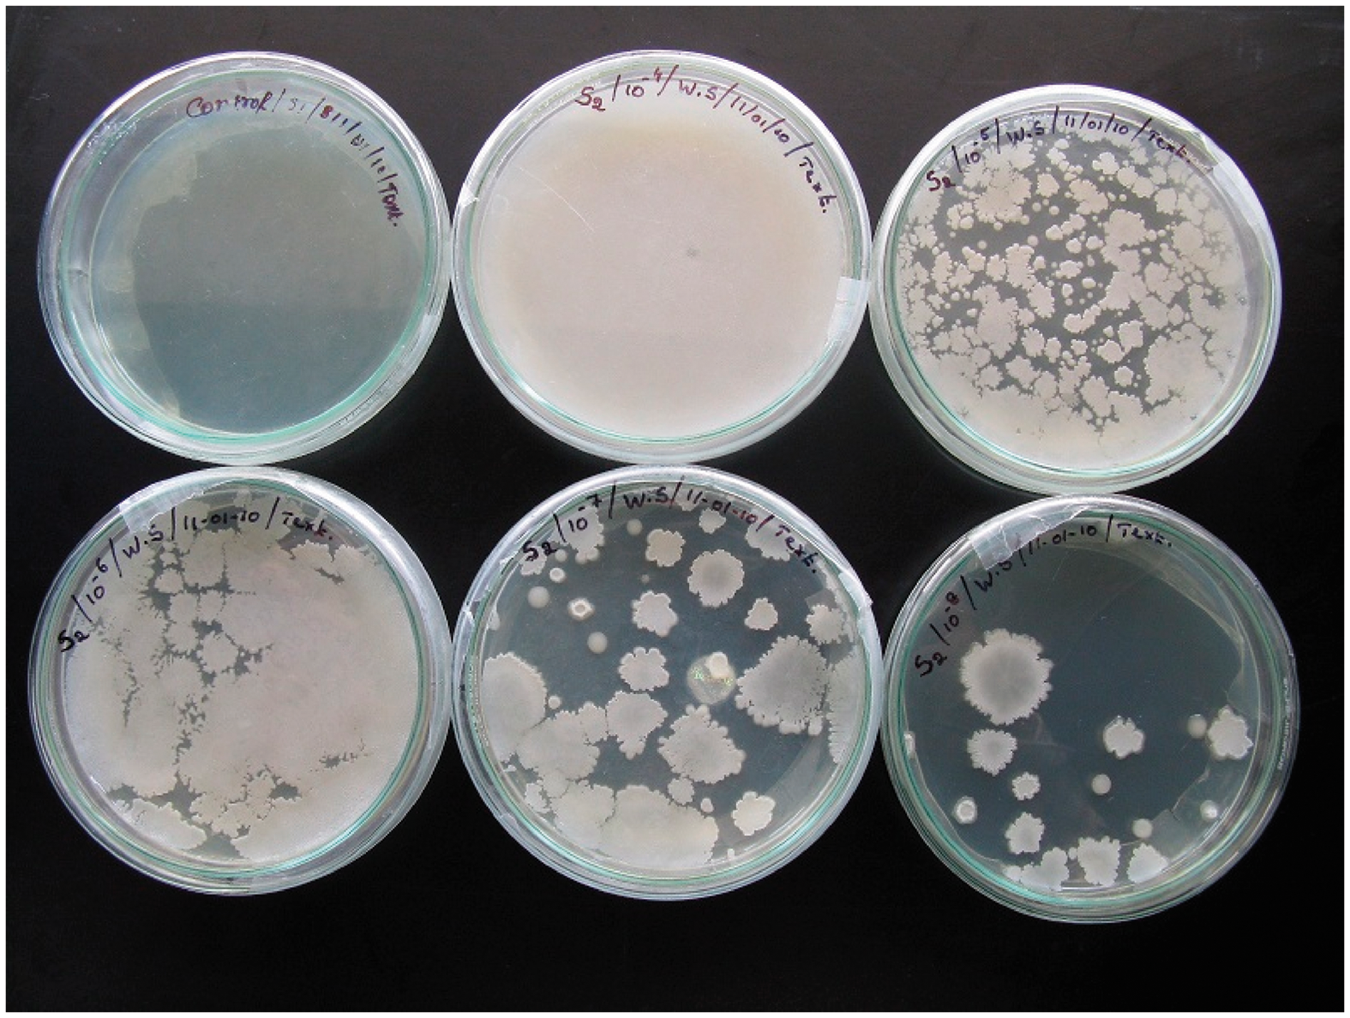
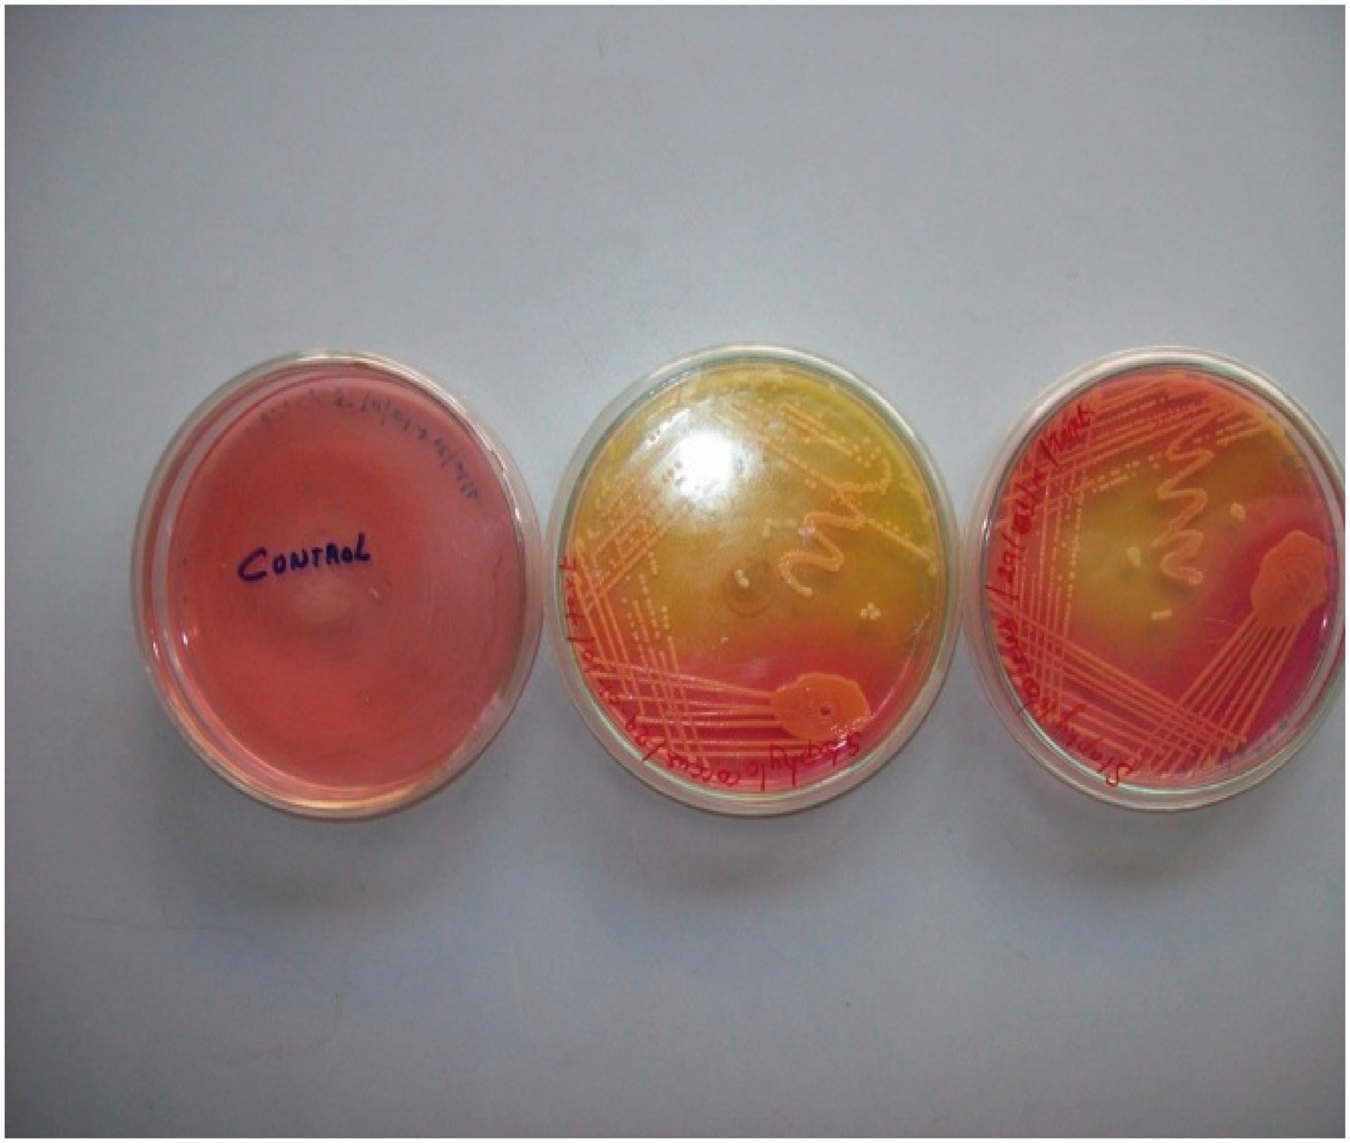
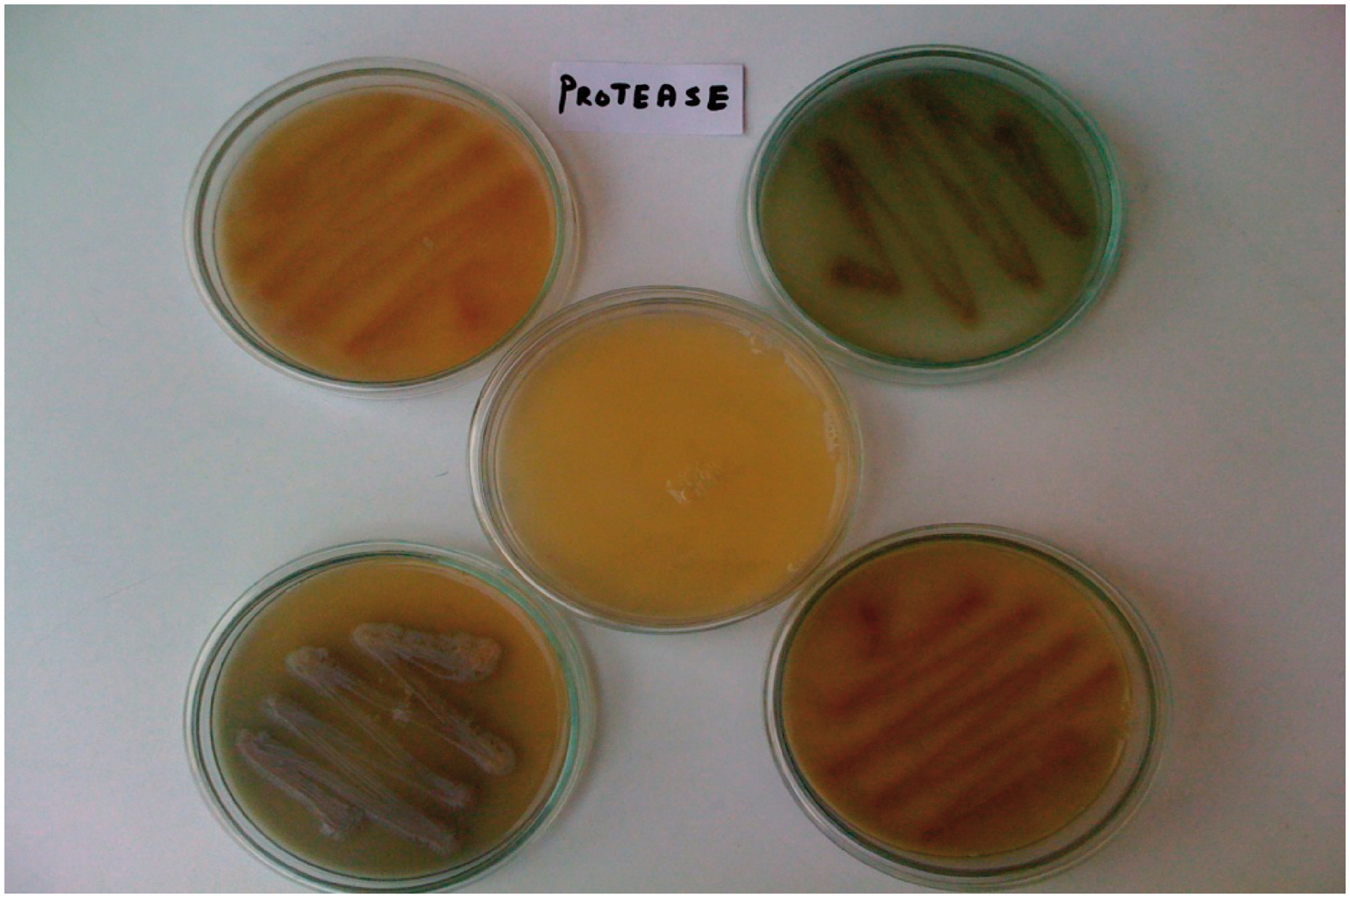
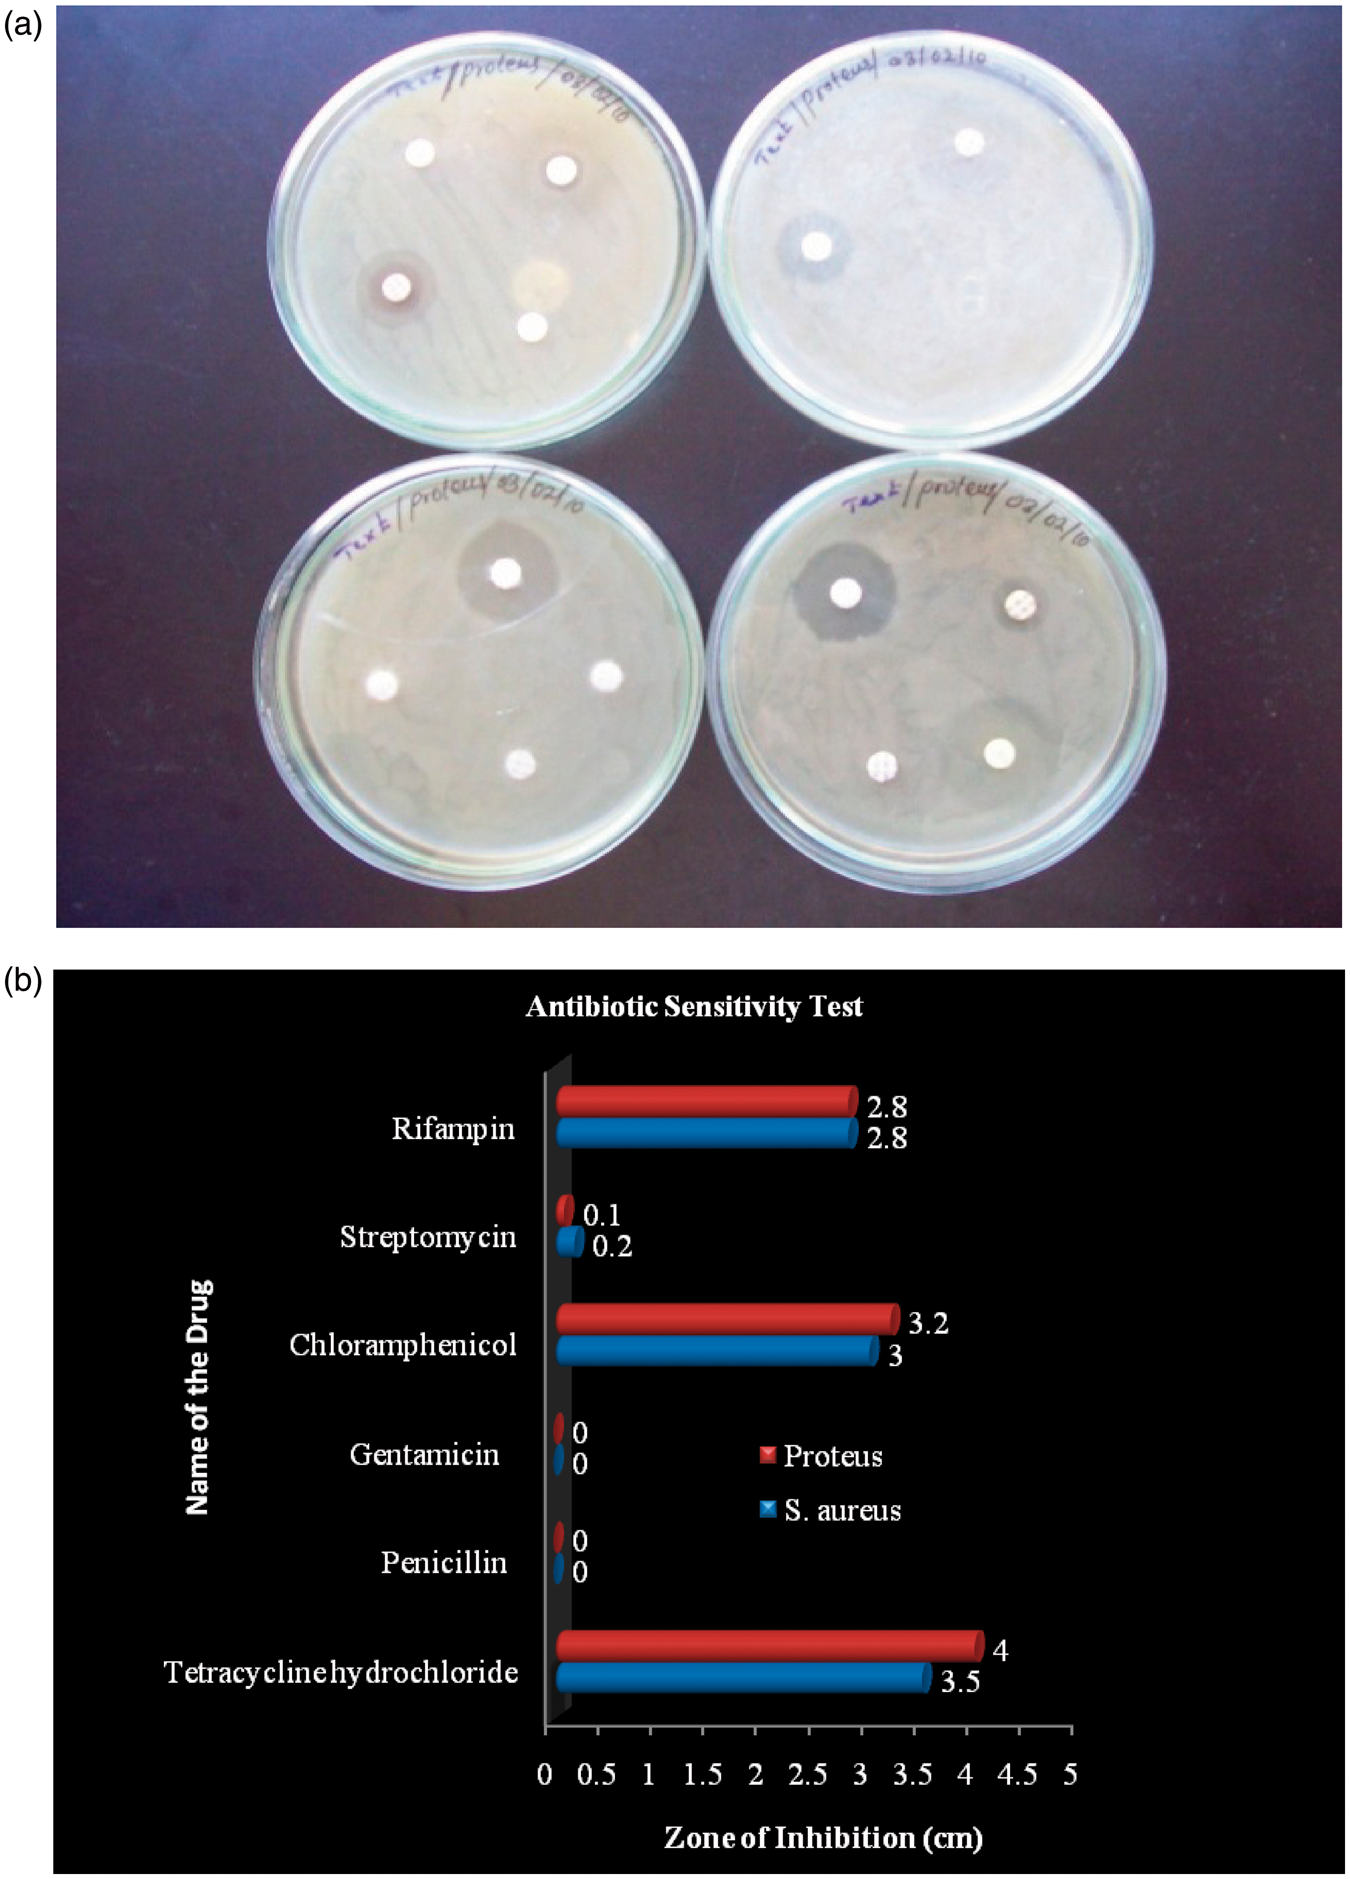

Abstract
This article deals with development and characterization of cotton and organic cotton flat knit bandages for wound healing. Bioploymers such as chitosan–sodium alginate, sodium–calcium alginate, and their mixtures were coated on the bandage and subjected to Fourier transform–infrared and scanning electron microscope analysis. Bacteria present in infected wound samples were identified using different bio-chemical methods. Three antibiotic drugs were selected based on the antibiotic sensitivity test and incorporated into the polymer-coated samples to improve the antibacterial and wound healing properties. Further, the antibacterial activities of the samples were evaluated against the identified bacteria in the wound for about 4 days. The strongest antibacterial activity was found in chitosan–sodium alginate–calcium alginate coated with chloramphenicol and tetracycline hydrochloride drug-loaded cotton and organic cotton samples. Hence, these bandages are suitable for quick wound healing process.
Introduction
In recent years, biodegradable polymeric systems have gained importance in the designing of surgical device, artificial organs, drug delivery system, and bandages. Demands placed on designing of dressings for healing of wounds to a large extent, met by biomaterials that contain healing-stimulating polymers [1]. The advances in wound healing science and biomaterial technology lead to varieties of wound dressing products available today. Among the wound dressing materials, bioactive dressings that contain bioactive substances seem to draw the greatest attention [2]. Chitosan and alginates having specific biological properties like hemostatic, granulation, and epithelization, are ideal materials for the construction of dressings suitable for wounds during the various healing phases [3]. Both polymers are biodegradable and obtained from the natural origin and having a good bio-adhesion [4], which is necessary for the more retention over the skin. The alginate as acidic linear polysaccharide composed of cell wall and intercellular cementing matrix algae can be converted into hydrophilic gel. This hydrophilic gel provides a moist wound environment which promotes healing and epidermal regeneration [5]. Calcium ions delivered from the alginates to the wound activate and accelerate homeostasis, due to the dressings having good exudates absorbency and hemostatic properties. Such materials are designed primarily for wound healing in the first phase [6]. HemCon bandage is a compressed chitosan acetate dressing that was developed as a hemostatic agent. Chitosan is a natural biopolymer that is derived from chitin, a major component of crustacean outer skeletons. This material is known in the wound management field for its hemostatic, bacteriostatic, and fungus static properties [7,8]. Compared to the constituent polymers, polyelectrolyte complexes (PEC) of oppositely charged polymers have advantages when applied as coating materials and controlled release delivery carriers [9]. Tetracycline hydrochloride is primarily bacteriostatic and is thought to exert its antimicrobial effect by the inhibition of protein synthesis. It is active against a wide range of gram-positive and gram-negative organisms [10]. Rifampin is used as antibacterial drug to treat or prevent infections that are proven or strongly suspected to be caused by bacteria [11]. It inhibits DNA-dependent RNA polymerase activity in susceptible cells. Specifically, it interacts with bacterial RNA polymerase but does not inhibit the mammalian enzyme. Chloramphenicol is an antimicrobial agent, used to combat serious infections where other antibiotics are either ineffective or contraindicated [12]. The objective of this research work was to develop flat knit bandages and compare the antibacterial activity against the identified bacteria in the wound samples. It is expected that the incorporation of antibiotic drugs will impart antibacterial and wound healing property to the bandage. Bandages coated with biopolymers followed by immobilization of antibiotic drugs have been used aiming at two layers of defense at the infected site.
Materials and methods
Materials
The cotton and organic cotton yarn (40 s Ne) was procured from Super Spinning Mills Ltd., Coimbatore. Chitosan (85% degree of deacetylation, Mw = 616,000 and η = 300 cps) was supplied by Central Institute of Fisheries Technology, Kerala. Calcium alginate and sodium alginate polymers were provided by Otto komi, Mumbai. Commercially available tetracycline hydrochloride (500 mg), chloramphenicol (500 mg), and rifampin (500 mg) drugs were purchased from market. They were used without further purification.
Methods
Measurement of flat knit fabric properties
The fabric property such as areal density was measured as per ASTM D 3776-07 method. Thickness, stiffness, and air permeability of fabrics were measured as per ASTM D 1777-96, ASTM D 1388-96, and ASTM D 737-96 standard test method.
Scouring and bleaching of flat knit fabrics
The cotton and organic cotton fabric was scoured using caustic soda (2%), soda ash (1%), wetting agent (1%), and other auxiliaries as per the standard procedure. These fabrics were bleached with hydrogen per oxide 4.0% volume and other auxiliaries as per the standard procedure described in the textbook [13]. The distilled water was used for the above processes.
Chitosan–sodium alginate polymer coating
Chitosan solution was prepared by stirring a dispersion of chitosan (8.0 g) in 2.0% (v/v) aqueous acetic acid solution for 1 hour at 60°C. Then, 2.0 g of sodium alginate polymer was added to the chitosan solution and stirred for 20 minutes. The cotton and organic cotton flat knit fabrics were padded twice with the solution of same concentration to a wet pick of 80%. The padded fabric was dried at 80°C for 5 minutes and cured at 140°C for 3 minutes.
Calcium alginate–sodium alginate polymers coating
Calcium alginate solution was prepared by stirring a dispersion of calcium alginate (8.0 g) in 4.0% (w/v) sodium carbonate solution (100 ml) for 30 minutes at 40°C. Then, 2.0 g of sodium alginate polymer was added to the solution and stirred for 20 minutes. The cotton and organic cotton fabrics were padded twice with the solution of same concentration to a wet pick of 80%. The padded fabric was dried at 70°C for 3 minutes and cured at 120°C for 5 minutes.
Chitosan–sodium alginate–calcium alginate polymer coating
Chitosan solution was prepared by stirring a dispersion of chitosan (8.0 g) in 2.0% (v/v) aqueous acetic acid solution at 60°C for 1 hour. Then, 2.0 g of sodium alginate polymer was added to the chitosan solution and stirred for 20 minutes. The cotton and organic cotton flat knit fabrics were padded twice with the solution of same concentration to a wet pick of 80%. The padded fabric was dried at 80°C for 5 minutes and cured at 140°C for 3 minutes. Further, the calcium alginate solution was prepared by stirring a dispersion of calcium alginate (8.0 g) in 4.0% (w/v) sodium carbonate solution (100 ml) at 40°C for 30 minutes. The chitosan and sodium alginate polymer-coated fabrics were padded twice with the calcium alginate solution of same concentration to a wet pick of 80%. The padded fabrics were dried at 70°C for 3 minutes and cured at 120°C for 5 minutes.
Fourier transform–infrared and scanning electron microscope analysis on polymer-coated samples
Fourier transform–infrared (FT–IR) spectra of the polymer-coated samples were recorded with KBr pellets on a FT–IR spectrophotometer (Horiba FT–210 Kyoto, Japan). The surface of the samples were observed under scanning electron microscope (SEM) (JEOL JSM 6340, Japan).
Identifying bacteria in wound samples
Wound samples were collected from three patients in Government Hospital at Tiruchengode. The samples were then mixed with agar medium and placed on a electronic shaker for about 3 days. It helps to grow the bacteria in the agar medium. The bacteria present in the samples were identified using different bio-chemical methods such as gram staining, mannitol agar plate, and phage typing, as described in the textbook [14].
Antibiotic sensitivity test
This test helps to select the drug for the appropriate line of treatment. The effectiveness is based on size of inhibition zone, as described in the textbook [14]. Six types of antibiotic drugs such as tetracycline hydrochloride, penicillin, gentamicin, chloramphenicol, streptomycin, and rifampin were selected and subjected to antibiotic sensitivity test against the identified bacteria in the wound samples.
Incorporation of antibiotic drugs
The drugs were selected based on the antibiotic sensitivity test. About 500 mg tetracycline hydrochloride, chloramphenicol, and rifampin antibiotic drugs were dissolved separately in 20 ml of distilled water. The polymer-coated cotton and organic cotton flat knit samples were immersed in the drug solution and allowed to remain stand still for 24 hours in the solution [15]. Finally, the samples were taken out, washed with distilled water, and dried at room temperature for 2 days. The drug add-on percentage was calculated using the following relationship:
Sterilization of polymer-coated and drug-loaded samples
Sterilization is the elimination of all transmissible agents such as bacteria, prions, and viruses from the material. The entire polymer-coated and drug-loaded fabric samples were sterilized in an autoclave at 120°C for 30 minutes [15]. The samples were taken out from the autoclave and subjected to antibacterial test.
Antibacterial test
The various polymer-coated, drug-loaded cotton, and organic cotton flat knit samples were tested for antibacterial activities against the identified bacteria in the wound samples for about 4 days. This test was performed according to the agar diffusion method [15]. The zone was measured using a zone of inhibition measuring gauge.
Results and discussions
Measurement of fabric properties
The variation in thickness of cotton and organic cotton flat knit fabrics before and after polymer coating was mentioned in Figure 1. From the result, it can be inferred that the thickness of cotton and organic cotton flat knit fabric was slightly increased after coating with polymers such as chitosan, sodium alginate, calcium alginate, and their blends. The thickness of uncoated flat knit structures varies from 0.039 to 0.041 mm and the polymer-coated structures ranges from 0.039 to 0.043 mm. The primary function of wound dressings is to avoid strikethrough and protect the wounded site from contamination and further injuries. This type of thicker bandages will give cushioning effect to the wound and also prevent from further injuries. The air permeability of cotton and organic cotton flat knit fabrics were measured before and after polymer coating with P1, P2, and P3 and the result was given in Figure 2. The air permeability of cotton and organic cotton flat knit fabric was decreased to a lesser extent after coating with polymers due to the blocking of gap between the threads. These fabrics maintain moist environment, which prevents the formation of scab as the dressing absorbs wound exudate secreted from the ulcer. An open wound, which is directly exposed to air, will dehydrate and a scab or escar is formed. This forms a mechanical barrier to migrating epidermal cells and is then forced to move in a deeper level of tissue, which prolongs the healing process.
Measurement of flat knit fabric thickness. Measurement of flat knit fabric air permeability.

Bacteria in wound samples
The bacteria present in wound samples were found out using different bio-chemical methods such as Serial dilution, Gram’s staining, Mannitol agar plate, and Phage typing. From Figures 3–6, it was found that Staphylococcus aureus and Proteus bacteria are present in the wound samples.
Unknown Bacteria 1 in wound sample. Unknown Bacteria 2 in wound sample. Bacteria 1 – S. aureus present in wound sample. Bacteria 2 – Proteus present in wound sample.

Antibiotic sensitivity test
Six types of antibiotic drugs such as tetracycline hydrochloride, penicillin, gentamicin, chloramphenicol, streptomycin, and rifampin were selected and subjected to antibiotic sensitivity test against S. aureus and Proteus bacteria. The results were given in Figure 7(a) and (b). It was found that tetracycline hydrochloride, chloramphenicol, and rifampicin drugs shows high sensitivity against the bacteria. The zone of inhibition was 2.8 to 3.5 cm against S. aureus and 2.8 to 4.0 cm against Proteus bacteria.
(a) Clear zone around the disc of the antibiotic drugs and (b) antibiotic sensitivity against S. aureus and Proteus Bacteria.
Polymer add-on on flat knit fabrics
A mixture of chitosan–sodium alginate (P1), calcium alginate–sodium alginate (P2), and chitosan–sodium alginate–calcium alginate (P3) was coated separately on flat knit fabric of cotton, and organic cotton was mentioned in Figure 8. A sample weight of 6 g was taken for the study. The biopolymers were prepared as per the procedure and coated on the bandages. Mixing the sodium alginate and chitosan solutions yielded a suspension of gel-like, clumpy coacervates, which gave rise to heterogeneous films. The surface of the film was relatively smooth on the fabric. A PEC system has been formed, while mixing chitosan with alginate solution. Such complex formation is expected to result mainly from electrostatic interactions between the amino groups in chitosan and the carboxyl groups in alginate. The chitosan aqueous solution was reacted with polyanion aqueous solution, such as carrageenan [16], sodium alginate [17], gelatin [18], and poly(acrylic acid) [19]. The formation of polyelectrolyte complex is mainly driven by an electrostatic mechanism, where charge neutralization and possible local overcompensation or bridging (such as hydrogen bounding, Coulomb forces, Van der Waals forces, and transfer forces) takes place [20]. Comparing with the constituent polymers, the PEC has advantages when applied as coating membranes and controlled release delivery systems [21]. The weight of the polymer add-on in grams was noted to estimate the polymer add-on percentage on flat knit structures. The polymer add-on on flat knit bandages was given in Figure 3. In all the flat knit structures, the coating of chitosan–sodium alginate–calcium alginate (P3) is found to have higher polymer add-on percentage compared to chitosan and sodium alginate (P1), calcium alginate, and sodium alginate (P2), respectively. The chitosan–alginate (PEC) have been shown to be water insoluble and proven more effective in limiting the release of immobilized materials compared to either polymer alone as stated by Yan et al. [22].
Polymer add-on on flat knit fabrics.
FT–IR and SEM analysis on polymer-coated samples
From Figure 9(a)–(c), it was found that a broad band at 3450 cm−1, a relatively sharp band at 2950 cm−1, and a fingerprint region from 1600 to 2950 cm−1 were recorded in the FT–IR spectra. It was also observed that the band at 3450 cm−1 in the chitosan polymer was shifted to 3300 cm−1 in the chitosan–sodium alginate polymer-coated sample. Resolution of two peaks was observed in the FT–IR spectrum of the calcium–sodium alginate-coated fabric. The sharp band at 3450−1 show the PEC formation in the polymer-coated samples. The SEM was used to observe the surface of the fabric and uniform distribution of polymers in the samples. It was clearly observed from Figure 10 photograph that the polymer entered into the fabric structure, which facilitates the antibacterial and wound healing properties of the bandages and also improves the absorbency of the medicine. The polymer was uniformly distributed throughout the samples. The surface of the film was relatively smooth on the fabric after the coating of polymers.
(a) FT–IR spectra of chitosan–sodium alginate polymer-coated sample, (b) FT–IR spectra of calcium alginate + sodium alginate polymer-coated sample and (c) FT–IR spectra of chitosan–sodium–calcium alginate polymer-coated sample. SEM photograph: (a) chitosan–sodium alginate-coated sample, (b) calcium–sodium alginate-coated sample, and (c) chitosan–sodium–calcium alginate-coated sample.

Antibiotic drug add-on
The polymer (P1, P2, and P3) coated flat knit fabrics were treated with antibiotic drugs of tetracycline hydrochloride, chloramphenicol, and rifampicin. Accurately weighted 4.0 g of polymer-coated sample was taken and the antibiotic drug was immobilized into the sample. The results were given in Figures 11–13. The drug add-on percentage was estimated and compared. In case of P1-coated cotton flat knit structure, chloramphenicol is found to have higher drug add-on next to rifampin and tetracycline hydrochloride, respectively. In case of P2-coated cotton flat knits, rifampicin is found to have a higher add-on compared with chloramphenicol and tetracycline hydrochloride, respectively. P1-coated cotton flat knit structures showed a higher tetracycline hydrochloride drug add-on of 98% next to chloramphenicol and rifampin drugs, respectively. Tetracycline hydrochloride antibiotic drug is found to have higher add-on percentage next to chloramphenicol and rifampin in the cotton and organic cotton flat knit samples. In case of organic cotton flat knit structure, a minimum drug add-on 93.8% (chloramphenicol) and a maximum drug add-on 98.2% (tetracycline hydrochloride) was found in P1- and P2-coated samples, respectively. In the case of cotton flat structure, a minimum drug add-on 89% (tetracycline hydrochloride) and a maximum drug add-on 98.2% (tetracycline hydrochloride) was found in P1- and P3-coated samples, respectively. P3-coated cotton and organic cotton flat knit structures observed more amount of drug than other samples. In general, drug add-on percentage was good in all the samples. Antibiotic is a substance or compound that kills or inhibits the growth of bacteria. It belongs to the broader group of antimicrobial compounds used to treat infections caused by microorganisms, including fungi and protozoa. These antibiotics diffuse out from antibiotic containing disks and inhibit the growth of bacteria resulting in a zone of inhibition.
Tetracycline hydrochloride drug add-on on polymer-coated flat knit samples. Chloramphenicol drug add-on on polymer-coated flat knit samples. Rifampin drug add-on on polymer-coated flat knit samples.


Antibacterial test
The polymer-coated and drug-immobilized cotton and organic cotton flat knit fabrics were subjected to antimicrobial effect against S. aureus and Proteus bacteria by agar diffusion test. The high zone of inhibition (diameter) indicates that the bacteria are very susceptible to these medicines. The antibacterial test was carried for about 4 days. The antibacterial activities of the polymer-coated and drug-loaded samples were clearly mentioned from Figures 14–17. The study shows that the zone of inhibition is 3.7–5.9 cm and 4.0–5.8 cm on the first day against S. aureus and Proteus bacteria. A minimum zone of inhibition 3.7 cm was observed in the chitosan and sodium alginate polymer-coated organic cotton flat knit sample and a maximum zone 5.9 cm was observed in the chitosan, sodium, and calcium alginate polymer-coated with rifampin drug-loaded cotton sample against S. aureus. In the case of Proteus bacteria, a minimum zone of inhibition 4.0 cm was observed in the chitosan and sodium alginate polymer-coated cotton flat knit sample and a maximum zone 5.8 cm was observed in the chitosan and sodium alginate polymer coated with chloramphenicol drug-loaded organic cotton sample. The zone of inhibition was slightly increased on the second day due to the release of drugs. The study was continued on the fourth day. It shows that the zone of inhibition is 4.0–6.5 cm and 4.2–6.3 cm against S. aureus and Proteus bacteria. The strongest antibacterial activity was found in the chitosan–sodium–calcium alginate coated with tetracycline hydrochloride and chloramphenicol drug-immobilized bandage samples. Most of the wound dressing materials are kept at the infected site for 4–5 days. A wound dressing which offers resistance for growth in this period can be considered for usage in these kind of applications. Even if the drug on the surface of the substrate is exhausted, polymer coating on the surface offers the second line of defense against bacteria.
Antibacterial activities of polymer-coated and drug-loaded cotton flat knit samples against S. aureus bacteria. Antibacterial activities of polymer-coated and drug-loaded cotton flat knit samples against Proteus bacteria. Antibacterial activities of polymer-coated and drug-loaded organic cotton flat knit samples against S. aureus bacteria. Antibacterial activities of polymer-coated and drug-loaded organic cotton flat knit samples against Proteus bacteria.



Conclusions
In this research work, cotton, and organic cotton yarn was used for the production of flat knit bandage. The fabric properties such as thickness, air permeability, and stiffness were measured as per the ASTM standard method. Biopolymers such as chitosan–sodium alginate, sodium–calcium alginate, and their mixtures were prepared and coated on the flat knit fabrics using padding mangle and the polymer add-on was calculated. The results indicate that good amount of polymer was coated on the fabrics, which improves the wound healing property of the bandage. The polymer-coated samples were subjected to FT–IR and SEM analysis. The FT–IR study reveals that PEC has been formed in the chitosan–alginate polymer-coated samples. The SEM photograph shows that the polymer was uniformly coated on the surface of the fabrics. Bacteria present in wound samples were found out using different bio-chemical methods; it was identified that S. aureus and Proteus bacteria were present in the wound samples. The antibiotic drugs such as tetracycline hydrochloride, rifampin, and chloramphenicol were selected based on the sensitivity test and incorporated into the polymer-coated samples. The results show that 90–95% of drug was added into the fabrics. The antibacterial activities of polymer-coated and drug-loaded samples were evaluated against the identified bacteria in the wound. The strongest antibacterial activity was found in the chitosan–sodium alginate–calcium alginate coated with chloramphenicol and rifampicin drug-loaded cotton and organic cotton flat knit samples. Hence, these bandages are judged to be most suitable for wound healing.
